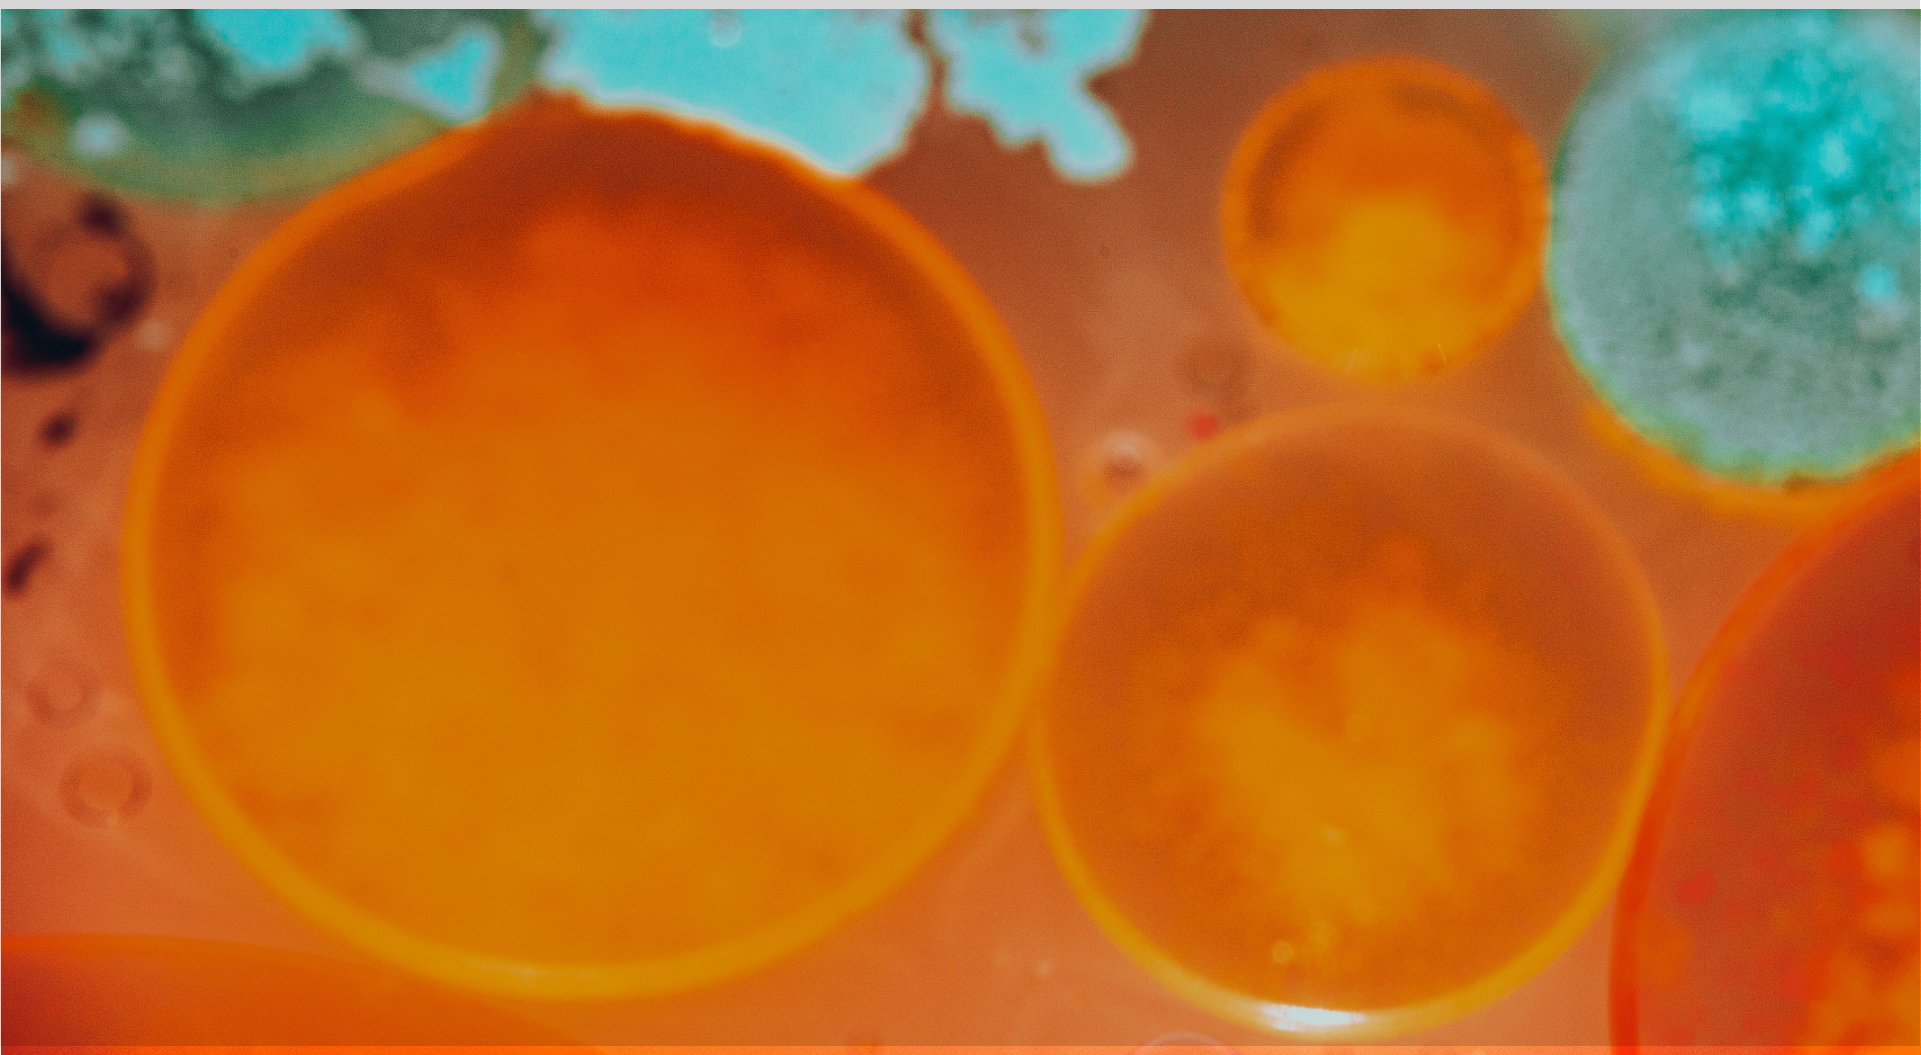

News and Updates
Live Blog: Arizona's Bioscience Roadmap
Welcome to the Flinn Foundation Bio Blog where you will receive the latest news throughout 2025 (and beyond) on the next iteration of Arizona’s Bioscience Roadmap.
The Roadmap is the nation’s longest-running, statewide bioscience strategic plan. Bookmark this page for regular updates on the biosciences in Arizona and the development of the new Roadmap coming this fall.
READ MORE
Live Blog: Arizona's Bioscience Roadmap
News and Updates
April 19, 2023
The Flinn Foundation hosted its annual online event April 19 to provide an update on the progress of Arizona’s bioscience ecosystem. The webinar featured remarks from Arizona Gov. Katie Hobbs, a conversation between mayors Kate Gallego of Phoenix, Regina Romero…
Read more
April 13, 2023
Phoenix announces addition of city’s third bioscience research hub / Phoenix Business Journal Phoenix Mayor Kate Gallego announced the city is getting its third bioscience hub designation—Phoenix Medical Quarter, Global Advancement of Health and Education at Park Central—building on its growing…
Read more
April 07, 2023
*This article first appeared in the Spring 2023 issue of Arizona Physician magazine, a publication of the Maricopa County Medical Society. Photo courtesy of Maricopa County Medical Society. By Brian PowellFlinn Foundation Arizona medical leaders are in a seemingly endless…
Read more
April 07, 2023
Award-winning Alzheimer’s researcher tapped to chair Flinn Foundation / Phoenix Business Journal Dr. Eric Reiman, CEO of Banner Research and executive director at Banner Alzheimer’s Institute, has been named chairman of the Flinn Foundation board of directors, replacing Dr. David…
Read more
April 04, 2023
The Flinn Foundation will host an online event from noon to 1:30 p.m. on Wednesday, April 19 to provide its annual update on the progress of Arizona’s bioscience sector. Gov. Katie Hobbs will offer remarks on the role of the…
Read more
March 30, 2023
Tempe medical device firm raises $45M to expand technology to treat brain tumors / Phoenix Business Journal (AZ Inno) Tempe-based GT Medical Technologies Inc. raised $45 million that will be used to expand the company’s commercialization of its GammaTile Therapy, a…
Read more
March 30, 2023
Dr. Eric Reiman, nationally recognized Alzheimer’s researcher, selected as new chair Dr. David Gullen, the longest-serving member of the Flinn Foundation board of directors, is stepping down as chair after 21 years of leading the philanthropic grantmaking organization. He will…
Read more